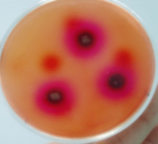
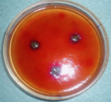
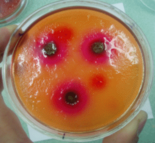

93536 (590122), страница 6
Текст из файла (страница 6)
Рисунок 5 - Результат исследования биологической доступности мази мумие с добавкой глицерина к бентонитовой основе (модель 3) На рисунках 6, 7, 8, 9 представлены результаты исследования биологической доступности мазей мумие моделей 1, 4, 5, 6.
По оставшимся четырем моделям мази проводили статистическую обработку, трех параллельно проведенных опытов, с учетом средней ошибке среднего арифметического, вычисляемого по формуле
К - величина, зависящая от числа вариантов (при п=3-0,29004).
Затем определяется среднее арифметическое (м) диаметров окрашенных зон трех параллельно проведенных опытов (мм)
а отклонение (а) данных каждого опыта от среднего арифметического (+1; - 1; 0). Цифровые значения отклонений (а) от среднего арифметического со знаком (+) и (-) суммируются, не обращая внимание на алгебраические знаки
а =2.
Пользуясь формулой
Вычисляют среднюю ошибку среднего арифметического
М =
(2*0,29004) = 0,58.
Таким образом, окрашенная зона исследуемого образца мази (1) через 30 мин ровна 13
0,58 мм. Аналогично обработаны все полученные данные и средние ошибки среднего арифметического диаметра для удобства использования занесены в таблицу 3.
Таблица 3 Средняя ошибка среднего арифметического
По полученным данным была построена зависимость
По средне арифметическим показателям, окрашенных зон исследуемых образцов мазей, был составлен рисунок 10.
Рисунок 10. - Динамика высвобождения мумиё в агар
График динамики высвобождения мумие в агар подтверждает отсутствие высвобождения мумие из мази в моделях № 2 и 3, поэтому для дальнейшего выбора состава мази мумиё из моделей No 1, 4, 5 и 6 мы определяем стабильность мази на расслаивание по методике описанной в пункте 2.2
Результаты исследования приведены в таблице 4 и на рисунке 11
Таблица 4 Расслаивание моделей мазей мумиё на основе бентонитовой глины при центрефугировании
| Модель мази об/мин. | 1 | 4 | 5 | 6 |
| 500 | Изменений нет | Изменений нет | Изменений нет | Изменений нет |
| 1000 | Изменений нет | Изменений нет | 1,5 мм | 1 мм |
| 2000 | Изменений нет | 2,5 мм | 3,5 мм | 13 мм |
| 3000 | 3 мм | 5 мм | 12 мм | 17 мм |
| 4000 | 4 мм | 7 мм | 15 мм | 19 мм |
Рисунок 11 - Динамика расслаивания мази мумие на основе бентонитовой глины
По данным таблицы 4 и графического рисунка 11 видно что наибольшей стабильностью обладает 1 модель мази мумие на основе бентонитовой глины так как ее расслаивание началось на более высоких оборотах, и в меньшей степени в отличии от других моделей мази. Наглядно разницу между моделями, мази мумие на основе бентонитовой глины, после проведения исследования на стабильность, при 4-тысячах оборотов в минуту, можно увидеть на рисунке 12.
6 модель 5 модель 4 модель 1 модель
Рисунок 12 - Результаты исследования стабильности мази мумиё на бентонитовой основе (модели 1,4,5 и 6)
Таким образом, нами выбран состав мази мумиё на бентонитовой глине с условным названием " Бенто М " (Вento M). Представленный в таблице 5.
Таблица 5 состав мази мумиё на бентонитовой глине " Бенто М "
(Вento M)
| Наименование ингредиентов | ||||
| Мумиё в% | Ланолин в% | Вода в% | Вазелин в% | Глина белая в% |
| 7,5 | 1,1 | 27 | 40,5 | 24 |
3.2 Технология мази "Бенто М"
Рациональная технологическая схема производства мази имеет следующий вид. Технологическая схема представлена на рисунке 13.
Стадии технологического процесса:
ВР 1 Подготовка сырья.
ТП 1 Получение мази мумиё на основе бентонитовой глины.
УМО 1 Фасовка мази мумиё на основе бентонитовой глины.
ВР 1 Подготовка сырья
ВР 1.1 Взвешивание мумиё. Для приготовления мази мумиё на основе бентонитовой глины отвешивают на весах мумиё.
ВР 1.2 Взвешивание воды. Для приготовления мази мумиё на основе бентонитовой глины отвешивают на весах воды.
ВР 1.3 Взвешивание вазелина. Для приготовления мази мумиё на основе бентонитовой глины отвешивают на весах вазелин.
ВР 1.4 Взвешивание ланолина. Для приготовления мази мумиё на основе бентонитовой глины отвешивают на весах ланолин.
ВР 1.5 Взвешивание белой глины производят на весах.
ТП 1 Получение мази мумиё на основе бентонитовой глины
ТП 1.1 Приготовление основы. В мазевых котлах, с наружной и внутренней паровой рубашкой, сплавляют вазелин с ланолином.
ТП 1.2 Растворение мумиё в воде. В котел с наружной паровой рубашкой и мешалкой помещают необходимое количество вода. Доводят до температуры 60-70оС и прибавляют мумиё. Перемешивают до полного растворения мумиё.
Рисунок 13 - Технологическая схема производства мази мумиё на основе бентонитовой глины
ТП 1.3 Добавление к основе раствора мумиё и белой глины. Горячий расплав переливают в смеситель, добавляют раствор мумиё, белую глину и тщательно перемешивают в течение 5-10 минут. Отбирают пробу для анализа в лаборатории контрольно - аналитических работ и стандартизации препаратов на соответствие требованиям, соответствующим нормам. Готовая продукция представляет собой мазь серо-коричневого цвета, со специфическим запахом мумиё и ланолина.
УМО 1 Фасовка мази мумиё на основе бентонитовой глины
УМО 1.1 Подготовка фасовочной тары.
Освобожденные от упаковочного материала банки из стекломассы ополаскивают снаружи и внутри проточной водопроводной водой для удаления механических загрязнений, затем замачивают в дезинфицирующем 3% растворе пероксида водорода с 0,5% раствором моющего средства, подогретом до температуры (50±10) ˚С в течение 15 минут.
После замачивания банки моют в этом же растворе с помощью ерша, затем ополаскивают не менее 5-7 раз в проточной водопроводной воде при температуре (50-60) ˚С и окончательно промывают водой очищенной. Контроль качества вымытой посуды проводят визуально по отсутствию посторонних включений и по равномерности стекания воды со стенок флаконов после их ополаскивания.
Полноту смываемости моющих средств определяют, ополаскивая испытуемую вымытую банку водой очищенной (банка заполняется водой полностью). Промывной водой смачивают ватный тампон, наносят на него 1 - 2 капли спиртового раствора фенолфталеина. Наличие остатков моющих средств даёт розовое окрашивание, которое должно отсутствовать.
Банки стерилизуют при температуре 180±10 ˚С в течение 60 ± 5 минут.
После снижения температуры в стерилизаторе до 60-70 ˚С банки вынимают и тотчас закрывают стерильными крышками. Срок сохранения стерильности изделий в бумаге упаковочной - трое суток, без упаковки используют непосредственно после стерилизации.
Пластмассовые навинчивающиеся крышки обрабатывают следующим образом: несколько раз промывают в горячей 50 ± 10˚С водопроводной водой и сушат в сушильном шкафу при температуре 50 - 60 ˚С.
Полиэтиленовые крышки обрабатывают следующим образом: несколько раз промывают горячей (50 ±10) ˚С водопроводной водой, затем ополаскивают водой очищенной и стерилизуют погружением свежеприготовленный 6% раствор пероксида водорода на 6 часов, после чего промывают водой очищенной и сушат в сушильном шкафу при температуре 50 - 60 ˚С.
Высушенные крышки хранят в закрытых биксах или стерильных банках с притертыми пробками не более трёх суток.
Мазь расфасовывают в банки из стекломассы с винтовой горловиной типа БВ-30-28-ОС по ОСТ 64-2-71-80, с навинчиваемыми пластмассовыми крышками типа 1.1-28 по ОСТ 64-2-87-81 и прокладками типа 2.1-28 по ОСТ 64-2-87-81 или прокладками картонными уплотнительными с двусторонним полиэтиленовым покрытием по ТУ 64-2-269-78.
УМО 1.2 Маркировка мази. На каждую банку наклеивают этикетку из бумаги этикеточной по ГОСТ 7625-86 Е или писчей по ГОСТ 18510-87 Е.